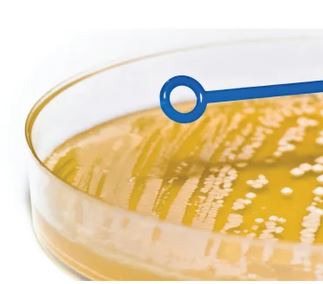

Description
Features and Benefits:
- Combination provides choice to spread or pick colonies and cultures.
- Transfer bacterial cultures without risk of contamination
- Use loop end to uniformly streak a gel surface
- Use needle end for removal of colonies
- Choose between flexible polypropylene or the more rigid ABS versions
- Disposable, sterile, 20 per bag with lot-to-lot traceability